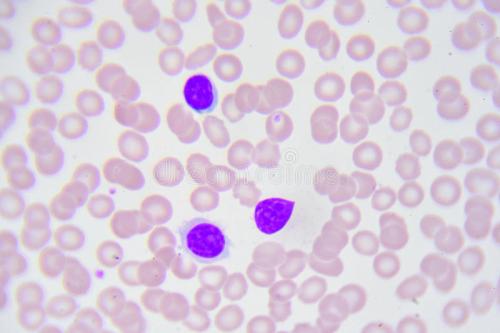

- 960化工网
- 上海沪峥生物科技有限公司
- 人肺大动脉内皮细胞(原代细胞)
¥1
上海沪峥
2021-09-07 00:19
我要认领上海沪峥生物科技有限公司
李经理微信同号
869248833@qq.com
产品属性
产品说明
人肺大动脉内皮细胞(原代细胞)细胞来源:ATCC/中科院/武汉细胞库等地引进
细胞名称:人肺大动脉内皮细胞(原代细胞)
种属来源:人生长形态:贴壁/悬浮
特征形态:详询我司客服
培养方法:详细资料请咨询客户经理,说明书请和客户经理联系上海沪峥生物一贯秉承以:诚信、创新、严谨、专业为宗旨,不断提高创新能力、服务能力,是您身边科研试剂最佳选择
CCC-HB-2细胞承诺:每一株细胞出厂前都经过严格处理及检查,保证细胞复苏2-3代内,免于细菌、真菌、支原体感染,保证成活率>95%。运输和保存可选择干冰运输及发送复苏存活细胞方式:1.干冰运输,收到后立即转入液氮或者-80度冰箱冻存或直接复苏;2.存活细胞,收到后应继续生长,传代达到细胞生长状态良好时,再进行冻存。具体操作见细胞培养步骤。细胞培养详细步骤收到常温细胞后处理方法收到细胞后首先观察细胞瓶是否完好,培养液是否有漏液、浑浊等现象,若有上述现象发生请及时和我们联系。1.用75%酒精擦拭细胞瓶表面,显微镜下观察细胞状态。因运输问题贴壁细胞会有少量从瓶壁脱落,先不要打开培养瓶盖,将细胞置于细胞培养箱内静置培养2-4小时,以便稳定细胞状态.2.仔细阅读细胞说明书,了解细胞相关信息,贴壁特性(贴壁/悬浮),细胞形态,所用基础培养基.血清比例,所需细胞因子,传代比例,换液频率等.3.静置完成后,取出细胞培养瓶,镜检,拍照,记录细胞状态(所拍照片将作为后续服务依据)建议细胞传代培养后,定期拍照,记录细胞生长状态.4.贴壁细:若细胞生长密度超过80%,可正常传代,若未超过80%,移除细胞培养瓶内培养基,预留5ML左右继续培养,直至细胞密度达80%左右再进行传代操作,瓶盖可稍微拧松.5.悬浮细胞:将细胞培养瓶内液体全部转移至50ML无菌离心管内,1200rpm离心5min,离心后上清培养基可收集备用,管底细胞沉淀加入5ml培养基吹打.重悬.镜检时,基细胞密度超过80%,可将细胞悬液分至2个细胞培养瓶内培养,补加培养基至5ml;若细胞密度未超过80%,将细胞悬液移至原瓶继续培养,直至细胞密度达80%左右时再进行传代操作.方 式: 详询经理细胞图片: 人肺大动脉内皮细胞(原代细胞)科研说明书内静置培养过夜,隔天再取出观察。此时多数细胞均会贴壁,若细胞仍不能贴壁请用台盼蓝染色测定细胞活力,如果证实细胞活力正常,请将细胞离心后用新鲜培养基再次贴壁培养;如果染色结果显示细胞无活力,请拍下照片及时和我们,信息确认后我们为您再免费寄送一次。1.请客户用相同条件的培养基用于细胞培养。培养瓶内多余的培养基可收集备用,细胞传代时可以一定比例和客户自备的培养基混合,使细胞逐渐适应培养条件;建议直接购买提供的完全培养基。
人肺大动脉内皮细胞(原代细胞)科研说明书内静置培养过夜,隔天再取出观察。此时多数细胞均会贴壁,若细胞仍不能贴壁请用台盼蓝染色测定细胞活力,如果证实细胞活力正常,请将细胞离心后用新鲜培养基再次贴壁培养;如果染色结果显示细胞无活力,请拍下照片及时和我们,信息确认后我们为您再免费寄送一次。1.请客户用相同条件的培养基用于细胞培养。培养瓶内多余的培养基可收集备用,细胞传代时可以一定比例和客户自备的培养基混合,使细胞逐渐适应培养条件;建议直接购买提供的完全培养基。
2.建议客户收到细胞后前3天各拍几张细胞照片,记录细胞状态,便于和技术部沟通交流。1.培养温馨提示:
(1)公司努力实现为科学研究提供实验细胞技术服务。所提供的实验细胞及其子代,不能用于人体实验和临床诊断、治疗。
(2)公司细胞资源中心承诺尽zui大努力对实验细胞资源相关信息进行及时更新。但限于我们的技术条件,中心不保证其准确性。
(3)从文献等处引用的信息本中心未进行核实,仅供参考。质量保障,售前售后全程跟踪人肺大动脉内皮细胞(原代细胞)相关细胞AR42J细胞;大鼠胰腺外分泌细胞产品名称: AR42J细胞;大鼠胰腺外分泌细胞
细胞数量: 1*10^6
组织来源:胰腺
细胞种属:大鼠源
生长特性:贴壁
培养基: F-12K+20%FBS
形态特征:上皮
传代方法: 1:3 - 1:4
培养条件:胎牛血清至最终浓度为10%。环境:空气,95%;二氧化碳(CO2),5%;温度,37℃
细胞描述:分泌活性可通过糖皮质激素刺激诱导,并伴随着内质网的广泛重组
细胞冻存:液氮冻存(冻存液基础培养基+20%FBS+10%DMSO)
细胞运输:干冰运输(2ml冻存管)或活细胞运输(T25瓶)ATDC5细胞;小鼠胚胎瘤细胞产品名称: ATDC5细胞;小鼠胚胎瘤细胞
细胞数量: 1*10^6
组织来源:胚胎
细胞种属:小鼠源
生长特性:贴壁
培养基: DMEM: Ham′s F12 (1:1) + 2mM Glutamine + 5%FBS
形态特征:上皮样
培养条件:胎牛血清至最终浓度为10%。环境:空气,95%;二氧化碳(CO2),5%;温度,37℃
细胞冻存:液氮冻存(冻存液基础培养基+20%FBS+10%DMSO)
细胞运输:干冰运输(2ml冻存管)或活细胞运输(T25瓶)B16 细胞;小鼠黑色素瘤细胞产品名称: B16 细胞;小鼠黑色素瘤细胞
细胞数量: 1*10^6
组织来源:皮肤
细胞种属:小鼠源
生长特性:贴壁
培养基: DMEM+10%FBS
传代方法: 1:4 -1:10
培养条件:胎牛血清至最终浓度为10%。环境:空气,95%;二氧化碳(CO2),5%;温度,37℃
细胞冻存:液氮冻存(冻存液基础培养基+20%FBS+10%DMSO)
细胞运输:干冰运输(2ml冻存管)或活细胞运输(T25瓶)
注意事项B16F10细胞;小鼠黑色素瘤细胞产品名称: B16F10细胞;小鼠黑色素瘤细胞
细胞数量: 1*10^6
组织来源:皮肤
细胞种属:小鼠源
生长特性:贴壁
培养基: DMEM+10%FBS
传代方法: 1:10
培养条件:胎牛血清至最终浓度为10%。环境:空气,95%;二氧化碳(CO2),5%;温度,37℃
细胞冻存:液氮冻存(冻存液基础培养基+20%FBS+10%DMSObiu-87细胞;人膀胱癌细胞产品名称: biu-87细胞;人膀胱癌细胞
细胞数量: 1*10^6
组织来源:膀胱
细胞种属:人源
生长特性:贴壁
培养基: RPMI-1640+10%FBS
形态特征:上皮
传代方法: 1:3
培养条件:胎牛血清至最终浓度为10%。环境:空气,95%;二氧化碳(CO2),5%;温度,37℃
细胞描述: BIU-87建系于1989年(俞莉章等)。该细胞系来源于人膀胱乳头状移行上皮癌,通常采用5×108细胞0.2ml接种裸鼠皮下,呈进行性肿瘤生长,肿瘤结节病检与原标本癌组织相似。22代细胞群体倍增时间为34小时。细胞能在软琼脂上生长,克隆形成率23%。BIU-87细胞系对ConA,WGA,PSL均有凝集反应。
细胞冻存:液氮冻存(冻存液基础培养基+20%FBS+10%DMSO)
细胞运输:干冰运输(2ml冻存管)或活细胞运输(T25瓶)BRL细胞;大鼠肝细胞产品名称: BRL细胞;大鼠肝细胞
细胞数量: 1*10^6
细胞种属:大鼠源
生长特性:贴壁
培养基: DMEM
细胞冻存:液氮冻存(冻存液基础培养基+20%FBS+10%DMSO)
细胞运输:干冰运输(2ml冻存管)或活细胞运输(T25瓶)质量保障,售前售后全程跟踪人肺大动脉内皮细胞(原代细胞)仅限科研使用C2C12细胞;小鼠成肌细胞产品名称: C2C12细胞;小鼠成肌细胞
细胞数量: 1*10^6
组织来源:肌肉
细胞种属:小鼠源
生长特性:贴壁
形态特征:成肌细胞
培养条件:胎牛血清至最终浓度为10%。环境:空气,95%;二氧化碳(CO2),5%;温度,37℃
细胞描述:该细胞株是Yaffe D, Saxel O建立的小鼠成肌细胞系的亚株。该细胞分化较快,可形成能收缩的微管,产生特异的肌肉蛋白。在骨形态形成蛋白(BMP-2)的作用下,该细胞可由成肌细胞分化为成骨细胞。检测发现该细胞鼠痘病毒阴性。
细胞冻存:液氮冻存(冻存液基础培养基+20%FBS+10%DMSO)
细胞运输:干冰运输(2ml冻存管)或活细胞运输(T25瓶)
注意事项C6细胞;大鼠神经胶质瘤细胞产品名称: C6细胞;大鼠神经胶质瘤细胞
细胞数量: 1*10^6
组织来源:脑
细胞种属:大鼠源
生长特性:贴壁
形态特征:成纤维细胞
传代方法:建议传代比例为1:2至1:3
培养条件:胎牛血清至最终浓度为10%。环境:空气,95%;二氧化碳(CO2),5%;温度,37℃
细胞描述: C6是由Benda等用N-亚硝基甲脲诱导的大鼠胶质瘤克隆,并经过一系列的体外培养和动物传代交替后建成的。该细胞表达S-100;产生生长激素;糖皮质激素作用下可以产生磷酸甘油脱氢酶。当细胞从低密度生长至回合状态时,S-100产量增加10倍。
细胞冻存:液氮冻存(冻存液基础培养基+20%FBS+10%DMSO)
细胞运输:干冰运输(2ml冻存管)或活细胞运输(T25瓶)case-17细胞;人宫颈腺癌细胞产品名称: case-17细胞;人宫颈腺癌细胞
细胞数量: 1*10^6
细胞种属:人源
生长特性:贴壁
培养基: DMEM
细胞冻存:液氮冻存(冻存液基础培养基+20%FBS+10%DMSO)
细胞运输:干冰运输(2ml冻存管)或活细胞运输(T25瓶)CBRH7919细胞;大鼠肝癌细胞产品名称: CBRH7919细胞;大鼠肝癌细胞
细胞数量: 1*10^6
组织来源:肝癌
细胞种属:大鼠源
生长特性:贴壁
培养基: RPMI 1640
形态特征:上皮细胞样
培养条件:胎牛血清至最终浓度为10%。环境:空气,95%;二氧化碳(CO2),5%;温度,37℃
细胞冻存:液氮冻存(冻存液基础培养基+20%FBS+10%DMSO)
细胞运输:干冰运输(2ml冻存管)或活细胞运输(T25瓶)
注意事项质量保障,售前售后全程跟踪人肺大动脉内皮细胞(原代细胞)仅限科研使用cgm1细胞;人EB病毒转化的B细胞产品名称: cgm1细胞;人EB病毒转化的B细胞
细胞数量: 1*10^6
组织来源:淋巴母细胞
细胞种属:人源
生长特性:悬浮
培养基: RPMI 1640
形态特征:淋巴细胞样
传代方法: 1:2。3天内可长满
培养条件:胎牛血清至最终浓度为10%。环境:空气,95%;二氧化碳(CO2),5%;温度,37℃
细胞冻存:液氮冻存(冻存液基础培养基+20%FBS+10%DMSO)
细胞运输:干冰运输(2ml冻存管)或活细胞运输(T25瓶)CNE-2细胞;人鼻咽癌细胞产品名称: CNE-2细胞;人鼻咽癌细胞
细胞数量: 1*10^6
组织来源:鼻咽癌
细胞种属:人源
生长特性:贴壁
培养基: RPMI-1640
细胞冻存:液氮冻存(冻存液基础培养基+20%FBS+10%DMSO)
细胞运输:干冰运输(2ml冻存管)或活细胞运输(T25瓶)cos7细胞;非洲绿猴肾细胞产品名称: cos7细胞;非洲绿猴肾细胞
细胞数量: 1*10^6
组织来源:肾
细胞种属:其他源
生长特性:贴壁
培养基: Dulbecco's Modified Eagle's培养基
形态特征:成纤维细胞
传代方法:建议传代比例为1:4至1:8
培养条件:胎牛血清至最终浓度为10%。环境:空气,95%;二氧化碳(CO2),5%;温度,37℃
细胞描述:这是一种非洲绿猴肾成纤维细胞样细胞系,适用于需要表达SV40 T抗原的载体进行转染。
细胞冻存:液氮冻存(冻存液基础培养基+20%FBS+10%DMSO)
细胞运输:干冰运输(2ml冻存管)或活细胞运输(T25瓶)
注意事项质量保障,售前售后全程跟踪人肺大动脉内皮细胞(原代细胞)仅限科研使用CT26-WT细胞;小鼠结肠癌细胞产品名称: CT26-WT细胞;小鼠结肠癌细胞
细胞数量: 1*10^6
组织来源:结肠
细胞种属:小鼠源
生长特性:贴壁
培养基: RPMI-1640培养基
形态特征:成纤维细胞
传代方法: 1:4至1:10
培养条件:胎牛血清至最终浓度为10%。环境:空气,95%;二氧化碳(CO2),5%;温度,37℃
细胞描述:该细胞系可以与CT26.CL25(ATCC CRL-2639)一起用作测试免疫疗法方案的模型以及用于宿主免疫应答的研究。
细胞冻存:液氮冻存(冻存液基础培养基+20%FBS+10%DMSO)
细胞运输:干冰运输(2ml冻存管)或活细胞运输(T25瓶)CTLL-2细胞;小鼠T淋巴细胞产品名称: CTLL-2细胞;小鼠T淋巴细胞
细胞数量: 1*10^6
组织来源: 36
细胞种属:小鼠源
生长特性:悬浮
培养基: RPMI-1640培养基
形态特征:细胞毒性T淋巴细胞;
培养条件:胎牛血清至最终浓度为10%。环境:空气,95%;二氧化碳(CO2),5%;温度,37℃
细胞描述:细胞依赖于IL-2进行生长,并可用于测定IL-2。
细胞冻存:液氮冻存(冻存液基础培养基+20%FBS+10%DMSO)
细胞运输:干冰运输(2ml冻存管)或活细胞运输(T25瓶)DC2.4细胞;小鼠树突状细胞产品名称: DC2.4细胞;小鼠树突状细胞
细胞数量: 1*10^6
细胞种属:小鼠源
生长特性:贴壁
培养基: RPMI-1640
细胞冻存:液氮冻存(冻存液基础培养基+20%FBS+10%DMSO)
细胞运输:干冰运输(2ml冻存管)或活细胞运输(T25瓶)质量保障,售前售后全程跟踪人肺大动脉内皮细胞(原代细胞)仅限科研使用DF-1细胞; 鸡胚成纤维细胞产品名称: DF-1细胞; 鸡胚成纤维细胞
细胞数量: 1*10^6
组织来源:胚胎,自发永生化
细胞种属:其他源
生长特性:贴壁
培养基: DMEM-H
形态特征:成纤维细胞样
传代方法:消化3-5分钟。1:2。3天内可长满。
培养条件:胎牛血清至最终浓度为10%。环境:空气,95%;二氧化碳(CO2),5%;温度,37℃
细胞冻存:液氮冻存(冻存液基础培养基+20%FBS+10%DMSO)
细胞运输:干冰运输(2ml冻存管)或活细胞运输(T25瓶)
注意事项E0771细胞;小鼠髓样乳腺癌细胞产品名称: E0771细胞;小鼠髓样乳腺癌细胞
细胞数量: 1*10^6
细胞种属:小鼠源
生长特性:贴壁
培养基: DMEM
细胞冻存:液氮冻存(冻存液基础培养基+20%FBS+10%DMSO)
细胞运输:干冰运输(2ml冻存管)或活细胞运输(T25瓶)EC9706细胞;人食管癌细胞产品名称: EC9706细胞;人食管癌细胞
细胞数量: 1*10^6
细胞种属:人源
生长特性:贴壁
培养基: DMEM
细胞冻存:液氮冻存(冻存液基础培养基+20%FBS+10%DMSO)
细胞运输:干冰运输(2ml冻存管)或活细胞运输(T25瓶)F81细胞;猫肾细胞产品名称: F81细胞;猫肾细胞
细胞数量: 1*10^6
组织来源:肾
细胞种属:其他源
生长特性:贴壁
培养基: RPMI 1640
传代方法:消化3-5分钟。1:2。3天内可长满
培养条件:胎牛血清至最终浓度为10%。环境:空气,95%;二氧化碳(CO2),5%;温度,37℃
细胞冻存:液氮冻存(冻存液基础培养基+20%FBS+10%DMSO)
细胞运输:干冰运输(2ml冻存管)或活细胞运输(T25瓶)质量保障,售前售后全程跟踪人肺大动脉内皮细胞(原代细胞)仅限科研使用FTC133细胞;甲状腺癌细胞 产品名称: FTC133细胞;甲状腺癌细胞
细胞数量: 1*10^6
细胞种属:人源
生长特性:贴壁
培养基: RPMI-1640
形态特征:上皮样
传代方法: 1:2~1:6传代;2~3天换液2次。
培养条件:胎牛血清至最终浓度为10%。环境:空气,95%;二氧化碳(CO2),5%;温度,37℃
细胞冻存:液氮冻存(冻存液基础培养基+20%FBS+10%DMSO)
细胞运输:干冰运输(2ml冻存管)或活细胞运输(T25瓶)G422细胞;小鼠脑神经胶质母细胞产品名称: G422细胞;小鼠脑神经胶质母细胞
细胞数量: 1*10^6
细胞种属:小鼠源
生长特性:体内生长
培养基: DMEM
形态特征:实体瘤
传代方法:制备成细胞悬液接种至Km等小鼠。
细胞冻存:液氮冻存(冻存液基础培养基+20%FBS+10%DMSO)
细胞运输:干冰运输(2ml冻存管)或活细胞运输(T25瓶)GBC-SD 细胞;人胆囊癌细胞产品名称: GBC-SD 细胞;人胆囊癌细胞
细胞数量: 1*10^6
组织来源:胆囊
细胞种属:人源
生长特性:贴壁
培养基: RPMI-1640
形态特征:形态上皮
传代方法: 1:2~1:6传代;2~3天换液1次。
培养条件:胎牛血清至最终浓度为10%。环境:空气,95%;二氧化碳(CO2),5%;温度,37℃
细胞描述: GBC-SD 细胞株是王展明等2000年从一位61岁的男性低分化胆囊癌患者中建立的。 细胞的形状有多边形、纺锤形和正方形。 分泌CEA和CA19-9。倍增时间大约为21.4小时。 可移植到裸鼠。 生成的肿瘤与原发肿瘤相似。
细胞冻存:液氮冻存(冻存液基础培养基+20%FBS+10%DMSO)
细胞运输:干冰运输(2ml冻存管)或活细胞运输(T25瓶)质量保障,售前售后全程跟踪人肺大动脉内皮细胞(原代细胞)仅限科研使用GC-1 spg细胞;小鼠精原细胞系产品名称: GC-1 spg细胞;小鼠精原细胞系
细胞数量: 1*10^6
组织来源:睾丸
细胞种属:小鼠源
生长特性:贴壁
培养基: DMEM
形态特征:形态上皮
传代方法:建议传代比例为1:6至1:10
培养条件:胎牛血清至最终浓度为10%。环境:空气,95%;二氧化碳(CO2),5%;温度,37℃
细胞描述:该线显示了B型精原细胞和初级精母细胞之间阶段的特征。 细胞表达两种睾丸特异性异蛋白,细胞色素c和乳酸脱氢酶C4。
细胞冻存:液氮冻存(冻存液基础培养基+20%FBS+10%DMSO)
细胞运输:干冰运输(2ml冻存管)或活细胞运输(T25瓶)GH3细胞;大鼠垂体瘤细胞产品名称: GH3细胞;大鼠垂体瘤细胞
细胞数量: 1*10^6
组织来源:垂体
细胞种属:大鼠源
生长特性:贴壁
培养基: F-12K
形态特征:形态上皮
传代方法:建议传代比例为1:2至1:4
培养条件:胎牛血清至最终浓度为10%。环境:温度,37℃;空气,95%;二氧化碳(CO2),5%;15%HS(马血清)
细胞描述:上皮样GH3克隆以比GH1细胞更高的速率产生生长激素,并且还产生催乳素。 对GH3细胞产生这些蛋白质激素的研究表明,氢化可的松刺激生长激素的生成并抑制催乳素的产生。 使用添加了15%马血清和2.5%FBS的Eagle最小必需培养基(Spinner)使细胞适应悬浮培养物的生长。在这些条件下,细胞继续产生生长激素和催乳素
细胞冻存:液氮冻存(冻存液基础培养基+20%FBS+10%DMSO)
细胞运输:干冰运输(2ml冻存管)或活细胞运输(T25瓶)质量保障,售前售后全程跟踪人肺大动脉内皮细胞(原代细胞)仅限科研使用GL261细胞;小鼠胶质瘤细胞产品名称: GL261细胞;小鼠胶质瘤细胞
细胞数量: 1*10^6
组织来源:胚胎
细胞种属:小鼠源
生长特性:贴壁
培养基: DMEM
形态特征:形态成纤维
传代方法:建议传代比例为1:100
培养条件:胎牛血清至最终浓度为10%。环境:空气,95%;二氧化碳(CO2),5%;温度,37℃
细胞描述:细胞含有编码命名为p185的185000道尔顿抗原的neu转化基因。 p185蛋白质与胶质母细胞瘤和成神经细胞瘤癌基因的存在密切相关。 neu癌基因与erb-B癌基因同源,并且p185与表皮生长因子受体在血清学上相似。
细胞冻存:液氮冻存(冻存液基础培养基+20%FBS+10%DMSO)
细胞运输:干冰运输(2ml冻存管)或活细胞运输(T25瓶)质量保障,售前售后全程跟踪人肺大动脉内皮细胞(原代细胞)仅限科研使用。